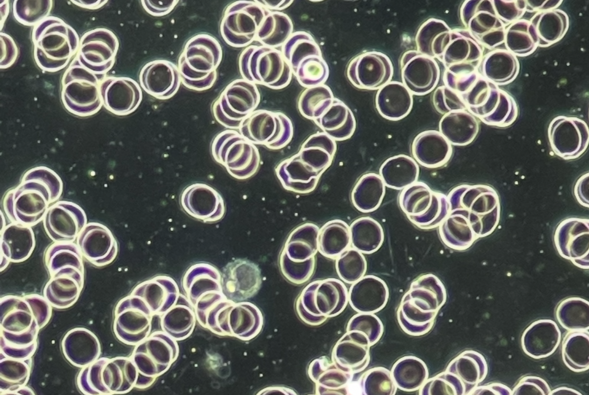
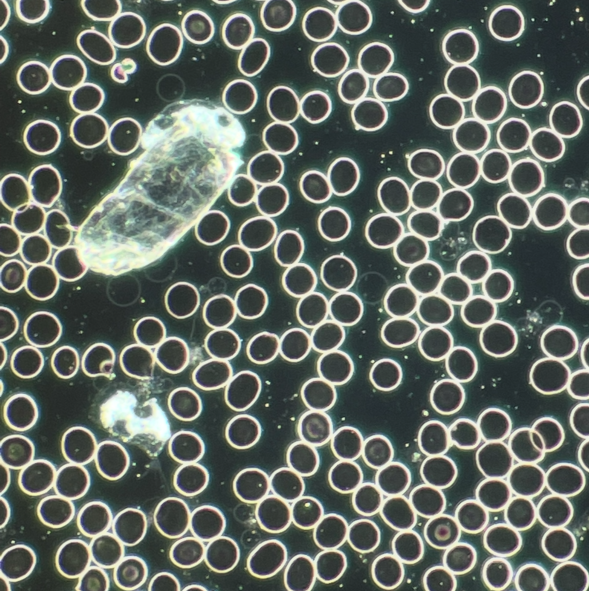

Dunkelfeldmikroskopie – Einblicke in das Blut, die weit über reine Laborwerte hinausgehen
Die Dunkelfeldmikroskopie bietet eine faszinierende Möglichkeit, das Blut in seiner lebendigen Struktur zu betrachten. Anders als in der klassischen Labordiagnostik, bei der Blutbestandteile hauptsächlich gezählt und quantitativ ausgewertet werden, richtet sich der Fokus im Dunkelfeld auf die Form, Beweglichkeit und Anordnung der Blutzellen.
Während herkömmliche Laborwerte wichtige Zahlen liefern, ermöglicht das Dunkelfeldmikroskop eine ergänzende Perspektive: Wir können unmittelbar beobachten, wie die Zellen aussehen – ihre Größe, ihre Form, ihre Vitalität und ihre Interaktion miteinander. Diese qualitativen Aspekte bleiben in der Standarddiagnostik meist unsichtbar.
Was kann im Dunkelfeld sichtbar werden?
– Form und Struktur der roten und weißen Blutkörperchen
– Plasmaqualität und Hinweise auf Belastungen
– Anordnung und Verhalten der Zellen im lebenden Zustand
– Auffälligkeiten, die auf Stoffwechselprozesse, Lifestyle-Faktoren oder Ungleichgewichte hindeuten können
Diese Beobachtungen ermöglichen eine ganzheitlichere Betrachtung, wie das innere Milieu aktuell arbeitet.
Wie nutzen wir diese Informationen?
Die Dunkelfeldmikroskopie ersetzt keine medizinische Diagnostik, kann aber wertvolle Hinweise liefern, um individuelle Gesundheits- und Lifestyle-Empfehlungen abzuleiten. Gemeinsam besprechen wir, welche Aspekte aus dem Blutbild auf bestimmte Bedürfnisse oder Belastungen hindeuten könnten.
Darauf aufbauend entwickeln wir Empfehlungen – zum Beispiel zu:
– gezielten Nährstoffen
– pflanzlichen Ergänzungen
– Ernährungsimpulsen
– alltagsnahen Maßnahmen zur Unterstützung des Wohlbefindens
Für ein besseres Verständnis des eigenen Körpers
Viele Menschen erleben die Dunkelfeldmikroskopie als besonders eindrucksvoll, weil sie ihr Blut live sehen und dadurch einen unmittelbaren Bezug zu ihrem eigenen Körper erhalten. Die Methode unterstützt ein tieferes Verständnis für die eigenen Gesundheitsprozesse und eröffnet neue Anknüpfungspunkte für eine bewusste, aktive Gesundheitsgestaltung.